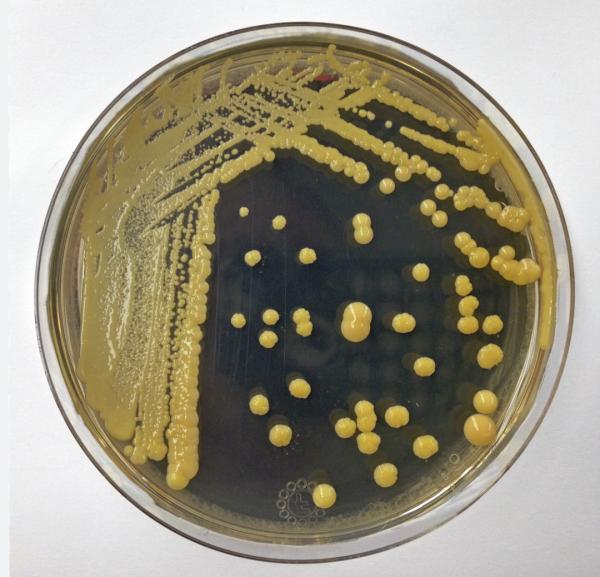

JB: A new report in USA Today is certainly looking for readers. The title clearly reflects this:
“Not 'if' but 'when': Antibiotic resistance poses an existential threat for modern medicine”
We’ve been reading the same headline since before you and I were working in infectious disease research some three decades ago. Is the headline legitimate, clickbait, or some of both?
DS: It’s both. This is true for a few patients – especially those with serious underlying diseases, those with cancer undergoing certain therapies, transplant patients, some post-operative patients, and, rarely, for those who are otherwise healthy. As the population ages, the number of patients at risk increases.
JB: So, the essence of the article – that we are all one strep throat away from death or serious illness because antibiotics no longer work – is exaggerated, correct?
DS: Yes, I would say that this is a correct statement.
JB: The CDC claims that 2.8 million people in the US develop antibiotic-resistant infections, accounting for 35,000 deaths – more when C. diff. has taken hold. What do these numbers tell us?
DS: First, including C diff – it’s probably more like three million infections and 43,000 deaths. This is from a 2019 CDC report. The numbers are outdated and have always been, in my view, an underestimate of the overall burden of antibiotic resistance. Don’t forget that this is not just a problem in the US. It’s a global issue. And globally the numbers today are staggering and will only get worse. Globally we’re probably talking about 5 million deaths per year. This number is on track to double by 2050 and by then will outpace cancer as a cause of death and will cause a $100 trillion loss in global GDP. Furthermore, these numbers do not account for additional morbidity, loss of days of work, infertility from resistant sexually transmitted infections, etc.
JB: Do you have a sense of how many lethal infections resulted from bacteria that are resistant to all antibiotics, rather than a patient who has a resistant infection simply dying despite being given an effective (or partially effective) drug, but were simply too sick to survive? In other words, are hordes of people dying because of infections for which there are no longer any effective drugs?
DS: It’s not so simple. The problem is that there is an increased mortality associated with any delay in the correct treatment of a serious infection. If a practitioner does not suspect the infection is resistant, the initial therapy will not be adequate. This occurs often in patients who might otherwise have survived their illness. We like to think of resistance as more of a continuum and that highly resistant infections are challenging, but often not impossible to treat. And yes, there are rare patients whose infections are truly resistant to all known therapies.
JB: More specifically, which pathogens are the most frightening in that they have developed resistance to most (or all) antibiotics and caused a significant difference in morbidity and mortality?
DS: The list is rather long actually.
- Serious Staph infections remain frightening.
- Gram-negative infections with Acinetobacter, Pseudomonas, and even some Klebsiella and E. coli can be very challenging.
- Then there is TB
- To say nothing about highly resistant infections with N. gonorrhea.
JB: Your blog, formerly Antibiotics - The Perfect Storm (now on Substack) started in 2009. The first entry is titled “The FDA - another blow to antibiotics?” Your criticism of FDA policies over the years is hardly a secret. Has your opinion changed?
DS: Yes. I think the FDA’s approach to the regulation of antibiotics has improved enormously since 2012. There are still areas where they could improve – especially in dealing with trials where the numbers will be small.
JB: Yet, your latest article, “A New Weapon Against Superbugs. Aztreonam-avibactam – Where has it been for the last 13 years?” is encouraging – a rare occurrence indeed. The FDA just approved Innoviva’s sulbactam-durlobactam (Xacduro) for hospital-acquired bacterial pneumonia. Is this a difference maker?
DS: Yes. But as I noted, the numbers of patients requiring these new therapies remains small. For them, it’s a matter of life and death. But for the broader market, the numbers just don’t work – the numbers of patients actually requiring these new therapies do not provide enough of a market. One study suggested that the market only had room for one such drug – but we need several.
The problem is that most of the antibiotics in the pipeline, including those that will make a difference (e.g. cefepime-tanoribactam) come from small biotech. The broken antibiotic marketplace almost guarantees that those companies will go bankrupt shortly after their product is approved. They will not earn enough revenue to make up their development costs and they will not be able to afford post-approval commercialization.
JB: What can be done to deal with this situation?
DS: We must have government support for the antibiotic marketplace. Without this – biotechs will go bankrupt further decreasing any private investment in antibiotic R&D with the result that our pipeline of new and needed antibiotics will simply disappear. The bipartisan PASTEUR Act currently before Congress would provide just such a fix – but I’m very skeptical that this congress will pass this desperately needed bill.
JB: The USAT article blames the Covid pandemic for causing extra antibiotic use, thus creating more resistance. Do you agree?
DS: Yes. This has been clearly demonstrated in a number of studies. Empiric antibiotic therapy for desperately ill patients spiked during Covid and did lead to an increase in resistance globally.
JB: Any closing thoughts?
DS: There are several things we can do to retard the inexorable increase in resistance. Antibiotic stewardship in the community, long-term care, and in hospitals will help. Decreasing antibiotic use in animals – especially on large commercial farms – will help. Decreasing antibiotic use in crops will help. More funding for antibiotic research will help. But none of this provides for an improved market – and that is what we need above all. We need the PASTEUR Act.
#Dr. Shlaes, author of Antibiotics, The Perfect Storm (Springer), and The Drug Makers
(Lulu), has had a forty-year career in anti-infectives spanning academia and industry with
a long-standing scientific interest in antimicrobial resistance. He trained in infectious
diseases at Case Western Reserve University in Cleveland. He then joined the faculty
and ultimately became a Professor of Medicine there. Dr. Shlaes left academia to become
Vice President for Infectious Diseases at Wyeth Pharmaceuticals in 1996. He was a
member of the Forum for Emerging Infections of the National Academy of Sciences for
seven years. In 2002, Dr. Shlaes became Executive Vice President, Research and
Development for Idenix, Pharmaceuticals, a company focused on the discovery and
development of antivirals. In 2005, he established a consulting company. During his
career years he contributed in significant ways to the discovery and development of
tigecycline, avibactam, eravacycline and lefamulin. Dr. Shlaes has since retired from
Anti-infectives Consulting. He writes a blog – Antibiotics the Perfect Storm on
Substack – and continues to be active in antibiotic policy areas. He is also a member of the ACSH Scientific Advisory Board.